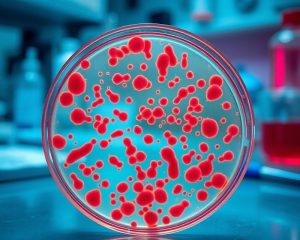

Ostatnie wpisy
- Prześlizgnięty dysk kręgosłupa: objawy neurologiczne, diagnostyka i leczenie zachowawcze lub operacyjne
- Borelioza: Objawy, diagnostyka i skutki zakażenia kleszczami
- Geriatria: kluczowe aspekty opieki nad osobami starszymi
- Wirusowe zapalenie wątroby: objawy, rodzaje i leczenie WZW
- Choroby grzybicze: przyczyny, objawy i skuteczne leczenie
Aktywność fizyczna i uroda
Archiwa
- maj 2026
- listopad 2025
- październik 2025
- wrzesień 2025
- czerwiec 2025
- maj 2025
- kwiecień 2025
- marzec 2025
- luty 2025
- styczeń 2025
- październik 2024
- czerwiec 2024
- kwiecień 2024
- luty 2024
- grudzień 2023
- listopad 2023
- październik 2023
- wrzesień 2023
- sierpień 2023
- lipiec 2023
- czerwiec 2023
- maj 2023
- kwiecień 2023
- marzec 2023
- lipiec 2022
- czerwiec 2022
- maj 2022
- luty 2022
- styczeń 2022
- październik 2021
- wrzesień 2021
- sierpień 2021
- maj 2021
- kwiecień 2021
- marzec 2021
- grudzień 2020
- listopad 2020
- październik 2020
- maj 2020
- kwiecień 2020
- listopad 2019
- październik 2019
- maj 2019
- marzec 2019
- luty 2019
- styczeń 2019
- maj 2018
- kwiecień 2018
- wrzesień 2017
- lipiec 2017
- czerwiec 2017
- maj 2017
- kwiecień 2017
- marzec 2017
- luty 2017
- styczeń 2017
- grudzień 2016
- listopad 2016
- wrzesień 2016
- sierpień 2016
- lipiec 2016
- czerwiec 2016
- maj 2016
- kwiecień 2016
- marzec 2016
- luty 2016
- styczeń 2016
- grudzień 2015
- listopad 2015
- październik 2015
- wrzesień 2015
- sierpień 2015
- lipiec 2015
- czerwiec 2015
Kategorie
Ciekawsze artykuły
Wiosenny makijaż – trendy, kolory i najlepsze techniki na sezonWiosna to czas odrodzenia, a jej przyjście zachęca nas do wprowadzenia świeżości nie tylko w garderobie, ale także …
Sprzęt do siłowniWybór odpowiedniego sprzętu do siłowni to nie tylko kwestia estetyki, ale przede wszystkim efektywności treningów i bezpieczeństwa. W …
Kto może otworzyć butik franczyzowy?Słowa butik franczyza i najmodniejsze ubrania mogą iść ze sobą w parze i okazać się nierozłączne. W dzisiejszych …
Używany sprzęt do siłowni – sprzęt do ćwiczeń fitnessW dzisiejszych czasach coraz więcej osób poszukuje oszczędnych i ekologicznych rozwiązań, które pozwalają na efektywne ćwiczenia w domowym …
Krem chłodzący po opalaniu – jak działa i jak go wybrać?Kiedy promienie słońca kuszą nas do spędzania czasu na świeżym powietrzu, często zapominamy o jednym z najważniejszych kroków …
Najnowsze komentarze